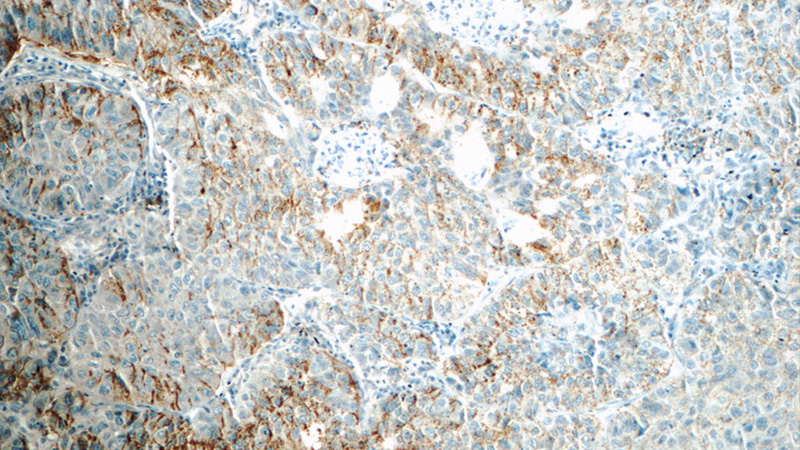
Immunohistochemistry of paraffin-embedded human lung cancer tissue slide using Catalog No:109605(CSPG4,NG2 Antibody) at dilution of 1:50 (under 10x lens)
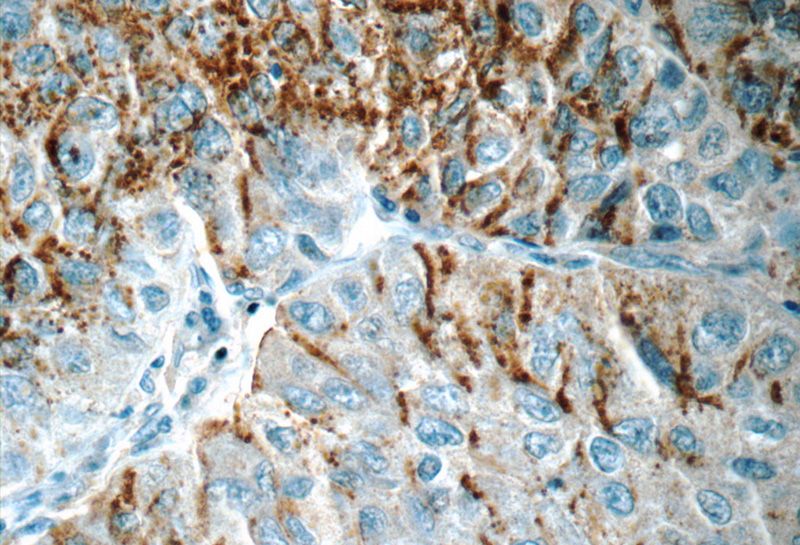
Immunohistochemistry of paraffin-embedded human lung cancer tissue slide using Catalog No:109605(CSPG4,NG2 Antibody) at dilution of 1:50 (under 40x lens)

-
Product Name
CSPG4,NG2 antibody
- Documents
-
Description
CSPG4,NG2 Rabbit Polyclonal antibody. Positive IHC detected in human lung cancer tissue. Positive WB detected in A375 cells. Observed molecular weight by Western-blot: 240-250kd
-
Tested applications
ELISA, WB, IHC
-
Species reactivity
Human,Mouse,Rat; other species not tested.
-
Alternative names
CSPG4 antibody; HMW MAA antibody; MCSP antibody; MCSPG antibody; MEL CSPG antibody; MSK16 antibody; NG2 antibody
-
Isotype
Rabbit IgG
-
Preparation
This antibody was obtained by immunization of Peptide (Accession Number: NM_001897). Purification method: Antigen affinity purified.
-
Clonality
Polyclonal
-
Formulation
0.1M NaHCO3, 0.1M glycine, 0.02% sodium azide and 50% glycerol pH 7.3.
-
Storage instructions
Store at -20℃. DO NOT ALIQUOT
-
Applications
Recommended Dilution:
WB: 1:500-1:5000
IHC: 1:20-1:200
-
Validations

A375 cells were subjected to SDS PAGE followed by western blot with Catalog No:109605(CSPG4,NG2 antibody) at dilution of 1:300
Immunohistochemistry of paraffin-embedded human lung cancer tissue slide using Catalog No:109605(CSPG4,NG2 Antibody) at dilution of 1:50 (under 10x lens)
Immunohistochemistry of paraffin-embedded human lung cancer tissue slide using Catalog No:109605(CSPG4,NG2 Antibody) at dilution of 1:50 (under 40x lens)
-
Background
CSPG4, also named as HMW-MAA, MCSP, MCSPG, MEL-CSPG, MSK16 and NG2, is a proteoglycan playing a role in cell proliferation and migration which stimulates endothelial cells motility during microvascular morphogenesis. CSPG4 may inhibit neurite outgrowth and growth cone collapse during axon regeneration. It is cell surface receptor for collagen alpha 2(VI) which may confer cells ability to migrate on that substrate. CSPG4 may regulate MPP16-dependent degradation and invasion of type I collagen participating in melanoma cells invasion properties. It modulates the plasminogen system by enhancing plasminogen activation and inhibiting angiostatin. CSPG4 functions as a signal transducing protein by binding through its cytoplasmic C-terminus scaffolding and signaling proteins. It promotes retraction fiber formation and cell polarization through Rho GTPase activation and stimulates alpha-4, beta-1 integrin-mediated adhesion and spreading by recruiting and activating a signaling cascade through CDC42, ACK1 and BCAR1. CSPG4 activates FAK and ERK1/ERK2 signaling cascades. The antibody is specific to CSPG4.
-
References
- Steinberg F, Gallon M, Winfield M. A global analysis of SNX27-retromer assembly and cargo specificity reveals a function in glucose and metal ion transport. Nature cell biology. 15(5):461-71. 2013.
Related Products / Services
Please note: All products are "FOR RESEARCH USE ONLY AND ARE NOT INTENDED FOR DIAGNOSTIC OR THERAPEUTIC USE"
